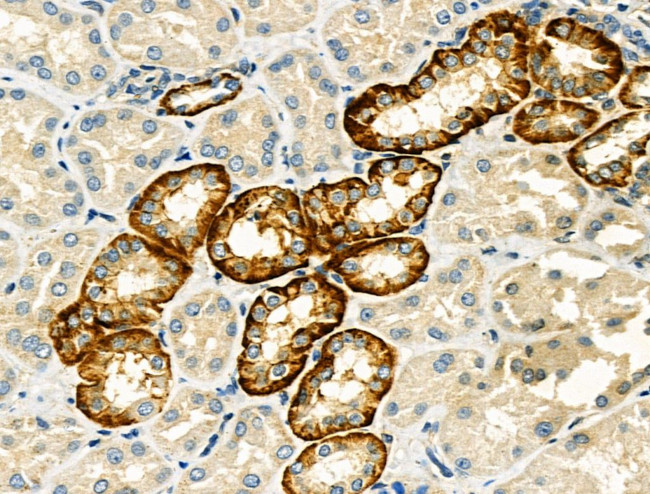
Connexin 45 Antibody in Immunohistochemistry (Paraffin) (IHC (P))

Search
Invitrogen
Connexin 45 Polyclonal Antibody
{{$productOrderCtrl.translations['antibody.pdp.commerceCard.promotion.promotions']}}
{{$productOrderCtrl.translations['antibody.pdp.commerceCard.promotion.viewpromo']}}
{{$productOrderCtrl.translations['antibody.pdp.commerceCard.promotion.promocode']}}: {{promo.promoCode}} {{promo.promoTitle}} {{promo.promoDescription}}. {{$productOrderCtrl.translations['antibody.pdp.commerceCard.promotion.learnmore']}}
图: 1 / 5
Connexin 45 Antibody (PA5-99394) in IHC (P)





Please note: We are reviewing Western blot images included in the antibody testing data in our catalog, including those provided by third parties. Unless expressly labeled or annotated as “raw-unedited”, Western blot images included in the antibody testing data in our catalog may have been edited, optimized or otherwise adjusted for presentation.
产品信息
PA5-99394
种属反应
宿主/亚型
分类
类型
抗原
偶联物
形式
浓度
规格
纯化类型
保存液
内含物
保存条件
运输条件
RRID
产品详细信息
Antibody detects endogenous levels of total Connexin 45 / GJA7.
靶标信息
Gap junctions were first characterized by electron microscopy as regionally specialized structures on plasma membranes of contacting adherent cells. These structures were shown to consist of cell-to-cell closely packed transmembrane channels. Proteins, called connexins, purified from fractions of enriched gap junctions from different tissues differ. Connexins are designated by their molecular mass. Another system of nomenclature divides gap junction proteins into 2 categories, alpha and beta, according to sequence similarities at the nucleotide and amino acid levels. For example, CX43 is designated alpha-1 gap junction protein, whereas CX32 and CX26 are called beta-1 and beta-2 gap junction proteins, respectively. This nomenclature emphasizes that CX32 and CX26 are more homologous to each other than either of them is to CX43. Connexins have four transmembrane, three intracellular, and two extracellular regions. Different tissues express different connexins, though tissue specificities overlap, and a given tissue or cell can express several different connexins. Developmental regulation of at least some of the connexin genes has been found. Embryo implantation is regulated in part by temporally changing patterns of expression of connexins in the embryo and the maternal decidua.
仅用于科研。不用于诊断过程。未经明确授权不得转售。
篇参考文献 (0)
生物信息学
蛋白别名: connexin 45; Connexin-45; CTC-296K1.4; Cx45; Gap junction alpha-7 protein; gap junction channel protein connexin 45; Gap junction gamma-1 protein; gap junction membrane channel protein alpha 7; gap junction protein, gamma 1, 45kDa; unnamed protein product
基因别名: C130009G16Rik; Cnx45; CX45; Cxn-45; Gja-7; GJA7; GJC1
UniProt ID: (Rat) A4GG66, (Mouse) P28229
Entrez Gene ID: (Human) 10052, (Rat) 266706, (Mouse) 14615